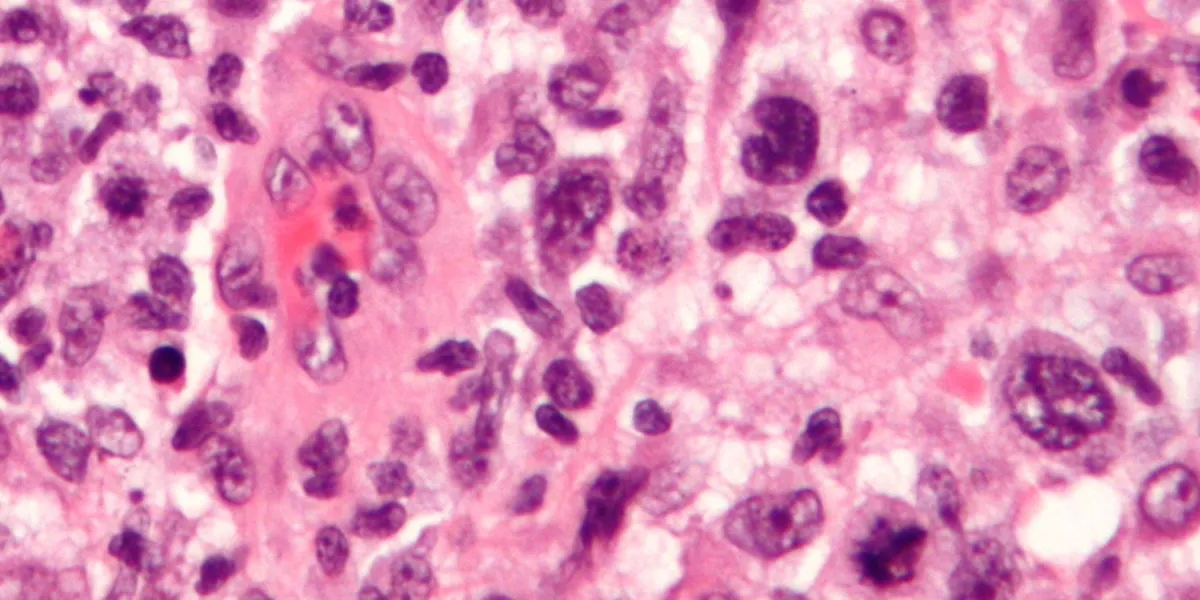

Cancer
Bienvenue dans notre rubrique Cancer, une source d'informations précieuses pour mieux comprendre et lutter contre cette maladie complexe. Nous vous proposons des articles détaillés, des conseils de prévention et des actualités pour vous informer sur les différents types de cancer, les traitements existants, les avancées scientifiques et les ressources disponibles pour les patients et leurs familles.
Dans cette rubrique, vous trouverez des articles sur les différents types de cancer, leurs symptômes, leurs causes et leurs facteurs de risque. Nous abordons également les méthodes de dépistage, de diagnostic et de traitement, en mettant l'accent sur les progrès réalisés grâce à la recherche et aux innovations médicales.

Cancer du sein

Cancer côlon-rectum
Cancer du col de l'utérus
Cancer : les traitements et l'évolution
Cancer de la prostate


Cancers ORL


Cancer du poumon

Cancer de la peau
Cancer de la langue
Cancer du foie

Cancer du pancréas